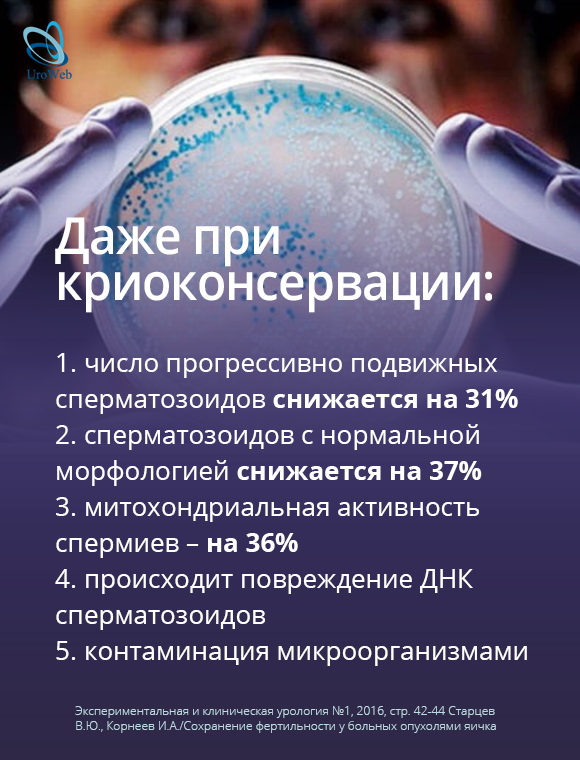
Фертильность у пациентов с раком яичка

Фертильность у пациентов с раком яичка
07.06.2019
3837
Важные новости
Последние новости